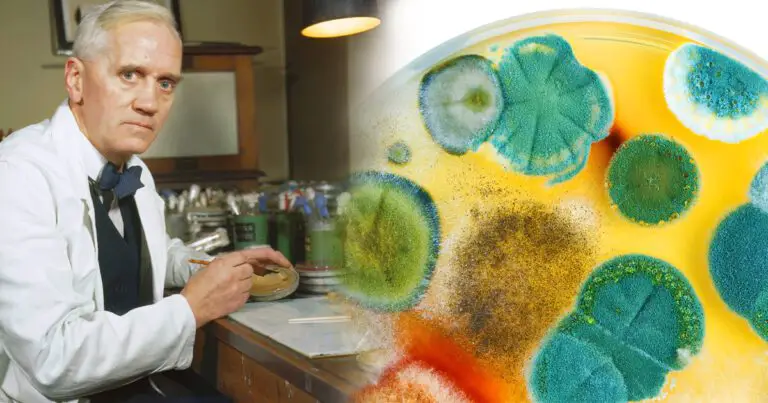

De ce oamenii din Antichitate nu percepeau culoarea albastru?

Culoarea albastru se află în mijlocul unui mister care leagă biologia, psihologia, arta și lingvistica. Mulți cred că modul în care vedem albastrul – adică ca o culoare distinctă – este de fapt o dezvoltare modernă. Pentru cei din trecut, conceptul…